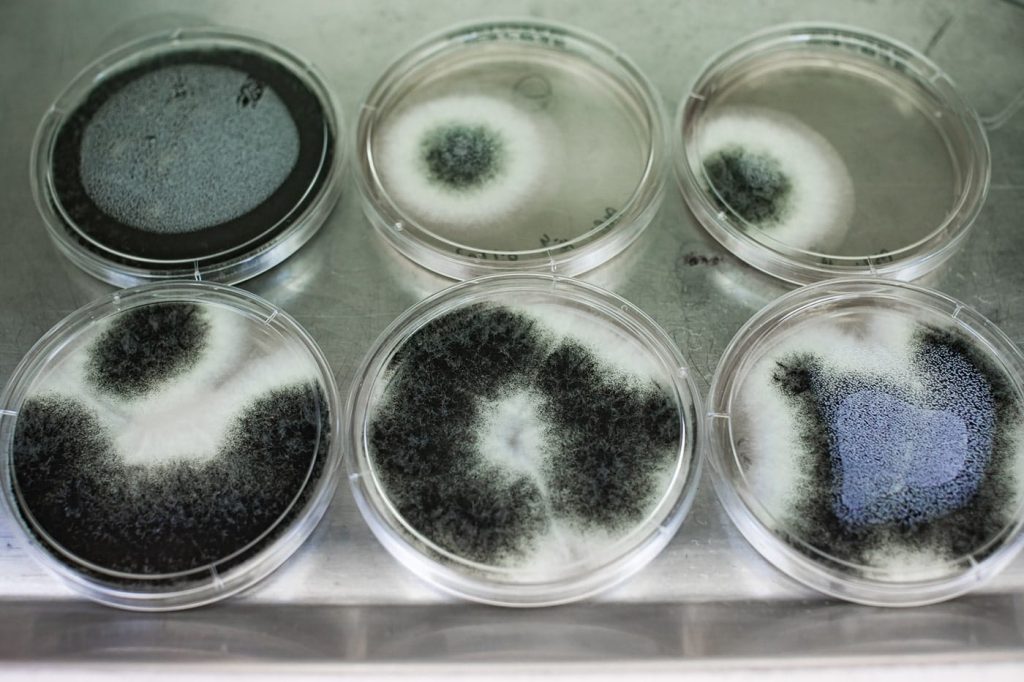
Mould Testing viable culture

Mould Testing
Speak to our SESALAB team for all your mould testing requirements
NATA accredited MouldLab providing fast turnaround on results


Mould Testing
Welcome to SESA, your trusted provider of Safety & Environmental Services in Australia. We specialize in Sample Analysis and Mould Testing, offering comprehensive assessments to identify and analyse mould contamination. With our commitment to excellence and state-of-the-art facilities, we ensure accurate and reliable results that enable you to effectively address mould-related issues.
Our team can provide you with results within the short time frame that you require. Laboratory analysis can be provided for :
Non-viable Mould in Air and Surface Samples
- Air-O-Cell, Allergenco-D, VersaTrap, Micro5, Filters (100% of sample deposit area analysed to reduce measurement uncertainty (MU))
- Biotape, Cellophane take, fungi tape, swab, bulk (100% of sample deposit area analysed to reduce measurement uncertainty (MU))
- Vacuum dust
Viable mould, yeast and Bacteria – identification and quantification of fungal cultures
- Air plates by impaction
- Settle plates
- Gelatin Filters
- RODAC Plates
- Swabs
- Bulk materials (carpet, timber, paper, cardboard, plasterboard, dust)
- Liquid (fluid, oil, water)
Read on to discover the benefits of choosing SESA for all your Mould Sample Analysis and Mould Testing needs.


To Submit your Samples for analysis
Sending Samples with Courier or Drop off
You can send the samples by Express Post, courier or drop of in person at reception or in the sample submission drop box located at the front door of our unit at:
SESA-Safety & Environmental Services Australia
Unit 53/3 Kelso Crescent, Moorebank, NSW, 2170
If you were unable to complete the chain of custody form prior to samples submission, you can obtain the form from SESALAB reception at the time of samples drop off.
Arranging Pickup From Work Site
Alternatively, for certain samples we can arrange pickup of your samples by courier with prior arrangement. A fee for the service would apply.
SESALAB accepts no responsibility or liability of costs on any samples damaged or lost in transit.
Samples Labeling & Packaging
Please ensure all samples submitted to SESALAB are correctly labelled with identifier and are safely packaged. The chain of custody form should accompany the samples batch. Alternatively, if not possible to complete the chain of custody form in time, the completed form can be emailed to lab@sesa.com.au. Note that the lab is unable to process samples without a completed chain of custody form.
State-of-the-Art Internal Laboratory: Quality and Efficiency
At SESA, we take pride in our NATA accredited internal laboratory, equipped with state-of-the-art technology and staffed by experienced professionals. Having an internal laboratory allows us to perform sample analysis efficiently and maintain complete control over the testing process. Our advanced equipment and techniques enable us to detect and identify mould species accurately, providing you with reliable data to assess the extent of contamination. With our streamlined approach, you can expect timely results without compromising on quality.
Comprehensive Mould Testing: Assessing Contamination Levels
Mould can pose significant risks to both the health of occupants and the integrity of buildings. At SESA, we offer comprehensive Mould Testing services to provide you with information for assessing the levels of mould contamination in the environment being investigated.
Experienced professionals follow industry-standard protocols to collect samples from various surfaces and air sources, allowing for a thorough assessment.
By analysing the samples in our NATA accredited laboratory, we provide you with detailed information about the types and concentrations of mould present reported at high level of confidence in the results with the least possible measurement uncertainty (MU), empowering you to make informed decisions regarding remediation and mitigation measures.
Expert Analysis and Interpretation: Insights for Effective Solutions
Our team of professionals at SESA includes experts in mould analysis and interpretation. Once the samples are analysed in our laboratory, our experienced analysts provide comprehensive reports that outline the findings and offer insights into the implications of the results. With their expertise, they can help you understand the potential health risks associated with the mould species identified and guide you in developing effective solutions to address the mould issue. Our goal is to provide you with the knowledge and support necessary to create a safe and healthy environment.
Would You Like to Know More
About Our Services
Call us today on 02 9822 8406, email us , or use our online enquiry form for further information about our services, to arrange an obligation-free
phone consultation or to discuss your requirements with us.
Tailored Solutions for Your Needs: Customised Testing Plans
We understand that each situation is unique when it comes to mould testing. That’s why we offer tailored solutions to meet your specific needs. Our team works closely with you to develop a customized testing plan based on the nature of the environment, suspected mould sources, and your specific concerns. Whether you require routine testing, pre-purchase assessments, or post-remediation verification, our experts have the knowledge and flexibility to provide the right solution for your mould testing requirements.
Choose SESA for Reliable Mould Testing and Sample Analysis
When it comes to Sample Analysis and Mould Testing, SESA is your trusted partner in Australia.

- Contact Us
Get A Quote

- Contact Us








